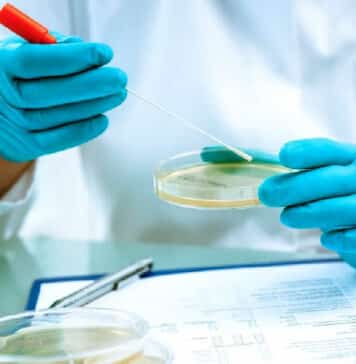
Syngene Quality Executive

Freshers Mol Bio Scientist Jobs at Thermo Fisher Scientific – Apply...
Scientist Job | Thermo Fisher
Thermo Fisher Scientific, the global leader in life sciences innovation, is hiring for the position of Scientist I, Molecular Biology...
BIRAC Funded Biotech & Biochem Project Job at CSIR-NCL
CSIR-NCL Pune Project Jobs For Biotech & Biochem
CSIR-NCL Pune Project Jobs For Biotech & Biochem. NCL Pune is hiring PhD Degree in Biotechnology, Biochemistry...
Project Associate Job at CSIR-NCL, MSc Biotech, Biochem & Microbiology Apply
Project Associate Job at CSIR-NCL, MSc Biotech, Biochem & Microbiology Apply
About CSIR-NCL: CSIR-National Chemical Laboratory (CSIR-NCL), based in Pune, is a premier research institution...
10+ BARC R&D Research Associate Fellowships Recruitment 2022
BARC Fellowships 2022 For Life Sciences, Biotech, Biochem, Mol Bio
BARC Fellowships 2022 For Life Sciences, Biotech, Biochem, Mol Bio. BARC Fellowships 2022 Recruitment. Bhabha...
Cytiva Scientist Role For Life Sciences, Biology & Biochemistry – Apply...
Cytiva Scientist Role For Life Sciences, Biology & Biochemistry - Apply Online
Scientist I SLS - Field Team
Cytiva
Hyderabad, India
Category: Customer Support
Job Id: R1270773
Location: Hyderabad, India
Be...
IIT Delhi is Hiring for Molecular Biologist, Microbiologist and Biochemist Roles...
Molecular Biology Jobs at Delhi - IIT Delhi Careers | Apply Now
Explore exciting Molecular Biology Jobs at Delhi with the Lab on a Chip...
11 R&D Jobs Vacant @ BioGene, GGI, NGS, BAID under (GSBTM)...
11 R&D Jobs Vacant @ BioGene, GGI, NGS, BAID under (GSBTM) Gujrat State Biotechnology Mission
Applications are invited for (i) Gujarat Biodiversity Gene Bank ...
COVID-19 Testing Lab Staff Recruitment With Rs. 54,000 pm Salary at...
ICMR-NIP Jobs For Lifescience - Rs. 54,300 pm Salary
ICMR-NIP Jobs For Lifescience - Rs. 54,300 pm Salary. ICMR-NIP, VMMC and Safdarjung Hospital Campus is...
ICMR-NIMR Non-Medical Scientist Job With Rs. 51,000 pm Pay For Biotech,...
NIMR Non-Medical Scientist Job With Rs. 51,000 pm Pay For Biotech, Biochem, Life Sciences & Microbiology
NIMR Non-Medical Scientist Job With Rs. 51,000 pm Pay...
IARI Biotech, Molecular Biology & Plant Biotech Research Fellow Job, Attend...
IARI Biotech Fellow Job: Eligibility, How to Apply, Important Dates, Selection Process, and Terms and Conditions
IARI Biotech Fellow Job: Eligibility, How to Apply, Important...
Centre for Stem Cell & Tissue Engineering Recruitment at Panjab University
Panjab University Project Post Vacancy Available
Panjab University Project Post Vacancy Available. Candidates with BSc & MSc Biochemistry/Biotechnology/Biophysics/Bioinformatics qualifications can apply for this vacancy at Panjab...
Govt HPPSC Scientific Officer DNA Recruitment 2022, Apply Online
Govt HPPSC Job Opening For Biochem, Biotech, Microbiology - Apply Online
Govt HPPSC Job Opening For Biochem, Biotech, Microbiology - Apply Online. Himachal Pradesh Public...
NIPER Project Associate Recruitment For Biotech, Biochem – Applications Invited
NIPER Project Associate Recruitment For Biotech, Biochem - Applications Invited
National Institute of Pharmaceutical Education and Research
(NIPER), Hyderabad
Balanagar, Hyderabad-500037, India
Advertisement for Project Associate-I
Applications are invited...
Unlock Your Career Potential as a Downstream Manufacturing-Junior Executive at Syngene...
Syngene Biotech & Biochem Executive Job - Downstream Manufacturing-Junior Executive
Job Description
Designation: Downstream Manufacturing-Junior Executive
Job Location: Bangalore
Department: Biopharmaceutical Operations
About Syngene
Incorporated in 1993, Syngene International Ltd....
University of Hyderabad JRF Recruitment For Eligible Candidates, Check Details
UoH JRF Recruitment For Eligible Candidates, Check Details
UoH JRF Recruitment For Eligible Candidates, Check Details. University of Hyderabad Junior Research Fellow job opportunity. Candidates...